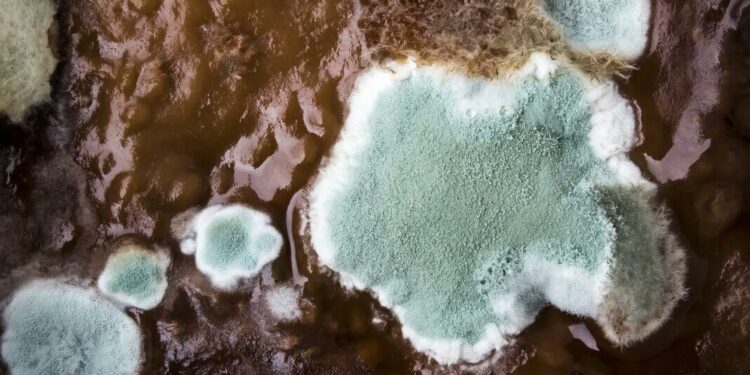

Les moisissures sont le signe d’une humidité trop élevée dans votre terrarium Ôtez les parties atteintes et laissez le contenant ouvert deux jours afin de renouveler l’air et de réguler l’hygrométrie Faites ensuite bien attention à ouvrir votre terrarium lorsque la condensation devient trop importante
Quand Faut-il ouvrir un terrarium ? Laisser ouvert 24h pour faciliter la cicatrisation enfin il est conseillé de renouveller l’air à l’intérieur en ouvrant le terrarium pendant 1 journée tous les 2/3 mois
Par ailleurs, Comment sauver un terrarium ? Le meilleur choix pour sauver votre terrarium est d’utiliser un mélange de sol adapté aux cactées comme celui-ci Pour les plantes succulentes, vous pouvez également utiliser un terreau de palmier ou d’agrumes Vous pouvez y ajouter quelques cailloux et graviers pour varier les couleurs
Du reste Comment vaporiser un terrarium ? N’hésitez pas à vaporiser la mousse avec un spray pour qu’ils gardent de l’humidité Les modèles semi-ouverts: (en forme de cloche) 1 arrosage 1 fois par mois Idem que pour les modèles ouverts, n’hésitez pas à vaporiser la mousse avec un spray pour remettre de l’humidité dans le terrarium
Pourquoi la mousse de mon terrarium devient marron ?
Si la mousse de votre terrarium devient marron par endroit, cela peut être le signe d’un début de moisissure lié à un surplus d’humidité dans votre terrarium Assurez-vous qu’il n’y ait pas un excès de condensation Un déficit en lumière naturelle peut également en être à l’origine
Comment bien entretenir un terrarium ?
– Un terrarium ouvert et humide soit être placer dans une pièce à température ambiante et éloigner des trop grandes sources de chaleur – Une fois votre écosystème créé, vous pouvez l’arroser 1 fois par semaine en hiver et 2 à 3 fois par semaine pendant l’été Pensez à observer la mousse
Comment nettoyer l’intérieur d’un terrarium ?
SI votre terrarium est verni, vous pouvez le nettoyer facilement avec du vinaigre blanc, ou un autre produit non nocif Dans le cas de terrarium OSB non vernis, vous pouvez utiliser les même produits mais avec plus de précaution Il ne faut pas en mettre trop pour éviter d’imbiber et abîmer le bois
Quelle eau pour terrarium ?
Afin de favoriser son développement, préférez l’eau de pluie ou l’eau minérale plutôt que l’eau calcaire du robinet Le terrarium ouvert et humide : Celui-ci réclame davantage d’attention Parce que l’air y circule plus facilement, il est plus difficile de maintenir l’humidité de la mousse
Où placer l’hygromètre ?
Placez-le à l’endroit où les symptômes de l’humidité sont le plus susceptibles de se manifester, dans la pièce qui vous préoccupe le plus ou bien là où votre famille passe le plus de temps Comme les hygromètres sont petits, il est possible de les changer de pièce de temps à autre
Pourquoi mon terrarium meurt ?
La cause du problème peut être soit un excès d’humidité, soit un manque d’arrosage L’excès d’humidité se caractérise par une condensation constante, votre terrarium peut éventuellement être lourd à soulever
Comment savoir si l’air est trop humide ?
En cas de doute : Scotchez une feuille d’aluminium au mur et attendez 48h Si de l’eau apparait sur le côté mur, c’est que l’humidité arrive par infiltration Si le coté pièce est mouillé, c’est que l’humidité se forme par condensation
Où placer le thermomètre dans un terrarium ?
Conseil : pour contrôler à tout moment la température à l’intérieur de votre terrarium, placez un thermomètre à chaque extrémité (un en zone chaude, l’autre en zone froide)
Comment construire un hygromètre ?
Pour sa fabrication, il vous faut deux thermomètres pour aquarium identiques, deux supports pour les soutenir (de la pâte à fixe fera très bien l’affaire), un petit morceau de tissu et un élastique Pour son utilisation vous aurez besoin d’un ventilateur
Quand ouvrir un terrarium ?
Si la condensation est trop importante ou que de l’eau ruisselle sur les parois, ouvrez votre terrarium pendant 24H afin de permettre l’évaporation du surplus d’humidité puis refermez-le Si le phénomène réapparaît, répétez l’opération jusqu’à obtenir un niveau de condensation raisonnable
Comment faire revivre un terrarium ?
Le meilleur choix pour sauver votre terrarium est d’utiliser un mélange de sol adapté aux cactées comme celui-ci Pour les plantes succulentes, vous pouvez également utiliser un terreau de palmier ou d’agrumes Vous pouvez y ajouter quelques cailloux et graviers pour varier les couleurs
Quelle mousse mettre dans un terrarium ?
Leucobryum glaucum, autrement nommée « mousse boule » est appréciée pour sa texture et sa belle couleur vert vif qui permet de constituer de beaux tapis en base de décor ; Pour le même emploi, pensez aussi à Riccia fluitans ; Si vous désirez un sujet un peu plus érigé choisissez Vesicularia reticulata